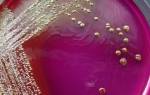

Опасность такого заболевания проявляется ещё и в том, что достаточно долгое время она проходит бессимптомно и человек зачастую даже не знает, что он болен. Конечно, есть определенные недомогания, но больной просто может не обращать на это внимания, так как постоянно занят или сильно устает. А тем временем болезненный процесс уже может быть в хронической форме, что совсем плохо.
Здесь уже начинаются нарушения эрекции, половое влечение значительно снижается. В лобковом районе начинаются болевые ощущения, процесс мочеиспускания проходит с крайне болезненными ощущениями. При этом часто и сильно болит голова, работоспособность падает, может начаться депрессия. Таким признакам нужно уделять повышенное внимание, так как дело может кончится уже не только урологическим болезнями, но и поражениями других органов.
Причины развития простатита
Практически каждый мужчина хоть раз встречается с проблемой воспаления предстательной железы. Лечением данной проблемы также занимается урология. Симптомы у мужчин могут быть ярко выражены или сглажены, в зависимости от формы протекания заболевания.
- Не забывать о гигиене – регулярный прием душа (не менее одного раза в сутки).
- Использовать исключительно индивидуальные средства гигиены.
- Не носить белье из синтетических и других ненатуральных материалов, что не позволяют дышать коже.
- Вести налаженную половую жизнь с одним партнером, избегать беспорядочных связей.
- Исключить из образа жизни вредные привычки.
- Пересмотреть рацион питания и исключить из него копчености, соления, жареную пищу.
- Начать нагружать свой организм различными физическими нагрузками в виде занятий в тренажерном зале, бегом, активными спортивными играми. Таким образом, исключаются застойные процессы в тазу и предстательной железе.
При появлении первых дискомфортных ощущений нельзя заниматься самостоятельной диагностикой и самолечением. Это может привести к непоправимым последствиям.
Урология – это такая дисциплина клинической медицины, которая изучает и исследует этиологию (происхождение), патогенез (развитие в болезнь) и диагностику (обнаружение) болезней органов мочеполовой системы, надпочечников и некоторых других органов в забрюшинном пространстве.
Урология располагается на ветви хирургии, так что, в основном, ее цель: лечение хирургическим путем вышеописанных органов и систем. В настоящее время в основном страдают от урологических недугов мужчины в возрасте от восемнадцати и до сорока пяти лет.
В 80% случаев заболевания долгое время не дают о себе знать, протекая бессимптомно. Ключевым фактором для проявления урологического заболевания может служить переохлаждение, субъективно тяжелая стрессовая ситуация.
Вот некоторые из распространенных урологических заболеваний:
- . Сильный воспалительный процесс слизистой оболочки мочевого пузыря. Как проявляется: преимущественно проявляется нарушениями при мочеиспускании, болевыми ощущениями в лобковой области. Причины: заражение (инфекция); переохлаждение. При отсутствии должного быстрого лечения возможно преобразование цистита в хроническую форму.
- . Процесс воспаления слизистой оболочки канала мочеиспускания. Характеризуется раздражающим зудом и жжением во время акта мочеиспускания.
Причины: инфекция из-за незащищённого полового акта.
- . Инфекционное воспаление мочеполовых путей. Большинство заболеваний урологического спектра способно развиваться бессимптомно, лечение долгое и трудное, т.к. возбудитель инфекции чрезвычайно устойчив к лекарствам.
- . По определению аденомой называется любое новообразование доброкачественной природы в тканях человека, которые содержат железистый эпителий. Применительно к мужским болезням, аденома простаты – самая печально известная.
Симптоматика ухудшается на протяжении первых трех лет постепенно: во время мочеиспускания мужчине приходится напрягать пресс, длительность мочевыделения увеличивается. Появляется боль при мочеиспускании и эякуляции. Если вовремя не принять меры, то опухоль станет злокачественной.
Причины: нездоровый образ жизни (вредные привычки, обилие в еде острого, газированного, соленого, исключение из еды растительной пищи).
- Мочекаменная болезнь. Как проявляется: частая нужда в мочеиспускании, сопровождаемая каждый раз болью, изменением цвета мочи. Причины: накопление солей в почках, может диагностироваться в любом возрасте, в течении продолжительного времени возможно бессимптомное течение.
- Пиелонефрит. Воспаление почек и почечной лоханки. Характеризуется повышением температуры тела, болями в области поясницы, общее недомогание. При отсутствии должного лечения воспалительный процесс в почке может привести к ее хирургическому удалению.
- Жжение.
- Непривычно затрудненное и учащенное мочеиспускание.
- Ощущение незавершенности опорожнения мочевого пузыря, субъективно мочевыделение оценивается как незаконченное. При этом, данный симптом часто сопровождается тем, что мочеиспускание необычно «маленькое» и быстрое, хотя субъективно кажется, что мочевой пузырь полон.
- Боль (часто острая и продолжительная) в нижней части живота.
- Воспаления, покраснения на полом органе.
- Изменение цвета мочи.
- Поясничные боли.
С профилактической целью следует отметить, что резко возросшая за последние года частота встречаемости урологических заболеваний у мужчин может быть обусловлена:
- Снижением иммунитета на фоне низкой экологии.
- Самолечением «народными» средствами.
- Бесконтрольным употреблением антибиотиков.
- Незащищенными половыми актами.
- Отсутствие наблюдения у уролога.
- Несоблюдение должных правил ухода за интимными частями тела, начиная с младшего возраста.
- Отсутствие элементарных знаний о профилактике урологических заболеваний.
Резюмируя, можно сказать следующее: урологические заболевания требуют профессионального хирургического вмешательства. Ни в коем случаем не занимайтесь самолечением, народной медициной – только навредите себе.
Занимается наука урология. Симптомы у мужчин могут встречаться различные, но чаще всего это боль, жжение и зуд при мочеиспускании. Урология определяется как хирургическая наука, так как занимается вопросами хирургического устранения причин, вызвавших развитие неприятных симптомов.
Многие мужские заболевания начинаются с быстро развивающегося воспалительного процесса. При баланопостите головка полового члена чешется и “горит”. Чувство жжения и зуда усиливается после акта мочеиспускания. Головка и внутренний листок крайней плоти сильно отекают, постепенно образуется поверхностная эрозия, из которой отделяется серозно-гнойное содержимое. Болезнь сопровождается общей слабостью, вялостью, повышением температуры.
Лечение необходимо начать незамедлительно, так как баланопостит часто приводит к фимозу и распространению инфекции на все органы мочеполовой системы.
Симптомы импотенции, коварного заболевания, сначала носят непостоянный характер, но затем приводят к серьезным проблемам, потому что мужчина больше не может вести полноценную половую жизнь. Отсутствие эрекции либо непродолжительная и слабая эрекция могут быть вызваны множеством причин: это и нервное истощение, и наркомания, и ожирение, и диабет, и даже элементарное умственное перенапряжение.
Для того чтобы лечение было эффективным, необходимо выяснить, что явилось толчком к резкому развитию мужского недуга. Если патология вызвана психическими причинами, эффективную помощь способен оказать врач-психотерапевт или психолог.
Применяются лекарственные препараты, которые вводятся в мочеиспускательный канал или в кавернозные тела полового члена путем инъекций. Если консервативные методы бессильны, то импотенция лечится хирургическими методами. Больному может быть показана сосудистая операция или протезирование полового члена.
Источник
Фимоз – детская болезнь
Сужение крайней плоти, при котором происходит склеивание листка крайней плоти с головкой полового члена, называется фимозом. Это явление наблюдается у детей 2-3-летнего возраста и постепенно исчезает. Но в некоторых случаях процесс задерживается, что приводит к формированию фимоза. Причинами заболевания могут стать перенесенные ранее инфекционные болезни, микротравмы, баланопостит и др.
При легких формах крайняя плоть с большими затруднениями, но все же обнажает головку полового члена, но при осложнениях это сделать невозможно. В последней, тяжелой стадии даже мочеиспускание затруднено, а моча скапливается в препуциальном мешке, после чего по маленьким каплям просачивается наружу. Если не лечить болезнь, могут возникнуть серьезные осложнения в виде острой задержки мочи, обостренной формы баланопостита и парафимоза, когда головка полового члена ущемляется и развивается некроз тканей.
Применение традиционных методов позволяет уменьшить признаки фимоза, но в большинстве случаев бессильно изменить ситуацию. К радикальным способам решения проблемы относится хирургическое вмешательство, при котором происходит иссечение крайней плоти (циркумцизия, обрезание). В некоторых случаях хирург проводит операцию, сохраняя крайнюю плоть.
Если произошел парафимоз, головку полового члена предварительно охлаждают, смазывают вазелином и вправляют. В случае когда эти действия не приводят к положительному результату, хирург выполняет рассечение ущемляющего конца.
Урология — область медицины, изучающая заболевания мочеполовой системы, которые встречаются у мужчин. С урологическими заболеваниями у мужчин следует обращаться к урологу. В большинстве случаев неполадки в мочевыводящей системе понижают самооценку представителей сильного пола и крайне негативно сказываются на организме. Часто заболевания переходят в хроническую стадию и могут незаметно прогрессировать.
Многие мужчины даже не подозревают о присутствующих нарушениях в мочеполовых функциях. Тем не менее, каждому человеку необходимо своевременно проходить обследование и при выявлении урологической болезни начинать лечение. Иначе в организме развиваются осложнения, а вылечить запущенную стадию гораздо труднее. Урологическое заболевание провоцирует бесплодие и импотенцию.
Также развиваются воспаления в мочевом пузыре (цистит) и почках (пиелонефрит). К урологическим относятся мочекаменная болезнь и различные нарушения в интимной сфере.
Обычно мужчины обращаются к врачу только при явно выраженных симптомах. Заболевания поджидают представителя сильного пола в любом возрасте. Поэтому каждому мужчине необходимо задуматься об урологических проблемах и следить за собственным организмом. При первых же нарушениях мочеиспускания, болях и резях требуется непременно посетить квалифицированного специалиста в поликлинике.
Урология: болезни, симптомы у мужчин
1. Венерические болезни:- сифилис- гонорея- трихомониаз и другие венерические инфекции.
2. Болезни воспалительного характера. Области поражения:- мочеиспускательный канал;- крайняя плоть и головка полового;- предстательная железа;- яички и их придатки;- мочевой пузырь;- паренхима почек и чашечно-лоханочная система;
3. Заболевание, связанное с камнеобразованием в почках (мочекаменная болезнь)
4. Заболевания интимной и репродуктивной сферы:- нарушение и отсутствие эрекции;- нарушение репродуктивной функции, ведущее к невозможности иметь потомство
5. Онкологическая патология:- аденома предстательной железы (новообразование простаты доброкачественного характера) и др.
Лечение урологической патологии необходимо сочетать со здоровым образом жизни. Пища должна быть разнообразной и полноценной. Иногда полезно применять бессолевую диету, чтобы вывести из организма лишнюю жидкость, тем самым снизить отечность. В ежедневный рацион обязательно должна быть включена белковая пища, оказывающая положительное влияние на репродуктивную функцию и на либидо.
Так же немаловажное значение имеет регулярная интимная гигиена наружных половых органов. Необходимо ежедневно принимать душ, если нет такой возможности, то хотя бы обмывать наружные полове органы, используя антибактериальный гель. Рекомендуется ежедневно менять нательное белье, которое, желательно должно быть из хлопчатобумажных тканей.
При половом контакте лучше всего использовать презерватив, чтобы защититься от проникновения в уретру болезнетворных микроорганизмов.
Очень важное значение, для мужского организма, имеет постоянная физическая нагрузка, занятие спортом и отказ от вредных привычек.
В связи с участившимися в последнее время случаями венерических заболеваний, посещать уролога для профилактического осмотра мужчинам необходимо не реже двух раз в год. Ведь именно при своевременно выявленном заболевании можно избавиться от него полностью.
При обращении в больницу врач должен провести первичный осмотр пациента и назначить необходимые лабораторные обследования. Во время осмотра врач сможет сразу определить, есть ли у мужчины какие-либо инфекционные или венерические заболевания. Также с помощью прощупывания простаты, проводящегося через прямую кишку, можно вовремя обнаружить и устранить развитие опухолевого процесса.
Определить возбудителя инфекции можно с помощью мазка, взятого из уретры. необходим для определения патогенной флоры, наличия скрытых инфекций и опухолей. Благодаря полученным результатам врач сможет назначить самое эффективное лечение, способное быстро устранить не только симптомы, но и возбудителя инфекции.
Проведение лабораторного мазка необходимо для определения наличия воспаления мочевого пузыря, простаты или уретры. Также он способен показать наличие уреаплазмоза, молочницы, хламидиоза, трихомониаза или микоплазмоза. Самые частые урологические заболевания у мужчин необходимо вовремя диагностировать, так как отсутствие своевременного лечения может вызвать серьезные проблемы со здоровьем.
Основные болезни мужской мочеполовой системы:
- уретрит,
- простатит,
- цистит,
- мочекаменная болезнь,
- баланопостит.
Их симптомы в чем-то схожи, но в чем-то различаются. Разберем эти заболевания более подробно.
Для быстрого и надежного улучшения потенции наши читатели советуют Спрей М16 . Это натуральное средство, которое комплексно воздействует на причины эректильной дисфункции. В состав «М16» входят только натуральные компоненты, обладающие максимальной эффективностью. Благодаря своему составу, препарат абсолютно безопасен, не имеет противопоказаний и побочных эффектов.
- болезненностью и жжением при выведении мочи;
- расстройствами мочеиспускания;
- выделениями из пениса;
- кожной сыпью на гениталиях;
- быстрой утомляемостью;
- болью при проведении полового акта;
- увеличенными паховыми лимфоузлами.
Нарушение эрекции для многих мужчин является запретной темой, о которой не принято говорить. Но все же это напрасно, поскольку нарушение эрекции не является большой редкостью в наше время. Примерно 50% мужчин старше 40 лет страдают, по меньшей мере, время от времени от эректильной дисфункции.
С возрастом процент мужчин с данной проблемой возрастает, причем нарушение эрекции может встречаться и у совсем молодых людей.
Причины разнообразны, но чаще всего виной всему становятся следующие из них:
- -психические факторы, такие, как стресс из-за ранее негативного опыта или страха получить отказ,
- -некоторые заболевания, например, сердечно-сосудистой системы или сахарный диабет,
- -повреждения нервов, например, при травме спинного мозга,
- -расстройства внутренней секреции,
- -побочные действия определенных медикаментов, например, психотропные средства, некоторые диуретики (фуросемид), гипотензивные препараты (каптоприл, клофелин, апрессин), бета-адреноблокаторы (атенолол, бетаксолол, бисопролол, метопролол, соталол и прочее), НПВС, эстрогены, антиандрогены, метоклопрамид, церукал и другие,
- -избыточный вес
- -алкоголь и никотин,
- -наркотические препараты.
Рак предстательной железы-это самый встречаемый вид рака у мужчин на сегодняшний день, ежегодно определяется около 60.000 новых случаев заболевания.
В большинстве своем страдают пожилые мужчины, средний возраст заболевших составляет 69 лет. Причем, что характерно, этот вариант рака может носить семейный характер, и если от него страдал близкий челн семьи, то и у остальных представителей мужского пола повышается риск заболеть раком предстательной железы.
Первыми симптомами при раке предстательной железы являются:
- -частые позывы помочиться,
- -болезненные ощущения при мочеиспускании,
- -медленный процесс мочеиспускания, слабый напор струи,
- -наличие крови в моче,
- -наличие крови в сперме,
- -болезненные ощущения в поясничном отделе позвоночника, боли в низу живота (над лоном) и во внутренней поверхности бедер,
- -эректильная дисфункция.
Что интересно, в странах, где в пищу употребляю много соевых продуктов, мужчины заболевают реже раком предстательной железы.
К симптомам заболеваний почек и мочевыводящих путей можно отнести субъективные проявления болезней, а также изменения в составе и структуре мочи, которые регистрируются во время лабораторных исследований. Пациенты в большинстве случаев жалуются на болевые ощущения и отеки. Боль в области мочевыделительной системы может быть острой и тупой.
При заболеваниях почек боль будет ощущаться в области поясницы, постепенно переходя в мочеточники. Иногда болевые симптомы возникают в половых органах, в паху и на внутренних бедренных поверхностях, что свидетельствует о воспалительном процессе в мочеполовой системе и тесной связи между почками и половыми органами.
О наличии мочекаменной болезни говорят схваткообразные боли в пояснице, а симптомами опухолей на почках, пиелонефрита и гломерулонефрита являются периодические тупые боли в области поясницы, которые усиливаются в вертикальном положении, во время физических нагрузок или тряской езде.
О наличии цистита говорят боли в мочевом пузыре и рези во время мочеиспускания. Симптомами уретрита являются болевые ощущения в мочеиспускательном канале (уретре). Заболевания почек характеризируются отечностью конечностей или лица. Симптомами в урологии можно назвать и нарушение в мочеиспускании. При данных заболеваниях возможно учащенное или затрудненное мочеиспускание, острая мочевая задержка или недержание мочи.
Урологические заболевания могут проявляться и такими общими симптомами, как: рвота, тошнота, общая слабость, повышение температуры тела, высокая утомляемость, болевые ощущения в области сердца, нарушение сердечного ритма и ухудшение зрения.
Определить возбудителя инфекции можно с помощью мазка, взятого из уретры. Урогенитальный мазок необходим для определения патогенной флоры, наличия скрытых инфекций и опухолей. Благодаря полученным результатам врач сможет назначить самое эффективное лечение, способное быстро устранить не только симптомы, но и возбудителя инфекции.
Ни один мужчина не застрахован от неприятных воспалительных заболеваний мочеполовой системы. Стоит отметить, что спообствовать возникновению таких заболеваний могут переохлаждение или нарушение правил личной гигиены, например.
И хотя в одной статье нельзя подробно рассказать обо всех болезнях и симптомах мужской урологии, мы постараемся ниже кратко рассказать наиболее важные для вас факты об этих недугах и их симптомах.
- Аденома простаты — это доброкачественная опухоль, возникает она у мужчин старше 30-35 лет.
- Простатит — заболевание предстательной железы.
- Уретрит — это заболевание мочеиспускательного канала, оно вызвано поражением стенки канала разного рода бактериями, вирусами.
- Цистит — это воспалительное заболевание мочевого пузыря.
- Эпидидимит — заболевание придатка семенника, оно характеризуется воспалительным процессом, припухлостью, отечностью и гиперемией в области мошонки.
Мужские урологические болезни могут проявляться болью, зудом, жжением, отеком, покраснением соответствующего отдела половой системы.
К примеру, аденома растёт медленно, и поэтому симптомы этого заболевания могут довольно долго не проявляться. Основные симптомы развития заболевания следующие: учащенное мочеиспускание; затрудненное мочеиспускание; небольшие порции мочи; чувство неполного опорожнения мочевого пузыря; в ночное время учащение мочеиспускания; вялость струи.
— высыпания, выделения и гиперемия мошонки и полового члена;
— боль, жжение и зуд;
— болезненность при совокуплении.
— чрезмерная утомляемость, слабость, вялость
— увеличение и уплотнение паховых лимфоузлов.
Если мужчина, активно живущий половой жизнью, выявляет у себя эти признаки, то ему немедленно нужно обратиться за помощью к дерматовенерологу и урологу.
Нередко недуги протекают асимптомно и остаются незамеченными до момента проявления осложнений. Однако специалисты выделили ряд схожих симптомов, предупреждающих о появлении урологических проблем.
Проблемы с мочеиспусканием — один из симптомов болезней по урологии у мужчин
Клиническая картина проявляется в следующих признаках:
- При осмотре наружных половых органов наблюдается покраснение, мелкая сыпь.
- Из полового члена выделяются нехарактерные выделения.
- Проблемы с мочеиспусканием.
- Болевые ощущения при сексуальном соитии либо после него.
- При пальпации прощупываются увеличенные лимфоузлы.
- Для общего состояния мужчины характерны слабость и быстрая утомляемость.
Одним из серьезных мужских недугов на сегодняшний день признано считать импотенцию. Ее проявления носят изначально непостоянный характер. Но спустя некоторое время мужчина начинает замечать явные проблемы с эрекцией, что приводят к невозможности вести нормальную половую жизнь. Провокаторами импотенции могут быть ожирение, употребление наркотиков и алкогольных напитков, нервное истощение.
Перед тем, как начинается лечение у больного исключается психическая причина импотенции. Для этого с пациентом работает врач-психотерапевт. И только если установлено, что недуг носит физиологическую причину, то применяют инъекции в кавернозные тела пениса. В крайнем случае, может быть назначена сосудистая операция.
Процентное соотношение причин импотенции
Симптоматика заболеваний
Современные мужчины все чаще встречаются с проблемами, устранить которые может только урология. Симптомы у мужчин, как правило, схожи, что позволяет быстро определить возбудителя инфекции и вылечить ее. Необходимо в срочном порядке посетить врача при обнаружении следующих симптомов:
- появление на половых органах покраснений, сыпи или специфических выделений;
- проблемы с мочеиспусканием;
- чувство боли, зуда или жжения при посещении туалета либо во время полового акта, в запущенной форме данные симптомы могут сопровождать мужчину постоянно;
- увеличение лимфоузлов, свидетельствующих о наличии в организме воспалительного процесса или инфекции;
- чувство постоянной усталости и быстрая утомляемость;
- проблемы в половой сфере, связанные с эрекцией, половой акт может сопровождаться сильной болью.
Необходимо учитывать, что большинство заболеваний протекают у мужчин в скрытой либо слабовыраженной форме, именно поэтому необходимо тщательно следить за своим мужским здоровьем, за соблюдением гигиены и ведением разумной половой жизни.
Уретрит представляет собой воспалительный процесс, локализующийся в тканях, образующих стенки мочевыделительного канала. К проявлениям уретрита можно отнести:
- режущие боли и жжение при посещении туалета;
- наличие специфических ;
- учащенные мочеиспускания;
- дискомфорт в нижней части живота;
- ощущение остаточной мочи.
Уретрит может быть следствием инфекции, поражающей непосредственно мочевыделительный канал, может возникать из-за травмы паховой области, особенно это касается мужчин молодого возраста, либо развиваться на фоне других инфекций, которые в запущенном виде мигрируют и вызывают воспаление мочевыделительного канала.
Основные симптомы заболевания, на которые в первую очередь необходимо обращать внимание:
- рези при мочеиспускании;
- проблемы с эрекцией и половым влечением;
- боль и дискомфорт внизу живота;
- частые головные боли;
- общая слабость организма;
- потеря работоспособности.
Диагностикой и устранением всех мужских проблем и занимается урология. Симптомы у мужчин, как правило, редко бывают сильно выраженными, так как большинство заболеваний протекает в скрытой форме. Поэтому необходимо внимательно следить за состоянием своего здоровья и образом жизни. Кроме этого необходимо отказаться от алкоголя и курения, нормализовать питание и принимать витаминные комплексы. Нормализовать кровообращение в предстательной железе поможет массаж.
Цистит представляет собой воспалительный процесс в мочевыводящих путях. Заболевание может возникать на фоне урологических или половых инфекций, камней в мочевыводящих путях или опухолей.
Основными симптомами являются рези и сильные боли при мочеиспускании, мутная моча, болезненность в области паха и половых органов. При тяжелом течении болезни возникает повышение температуры тела, кровь в моче, неприятный запах гнили.
Мужская урология (симптомы и лечение конкретных недугов обычно зависят от степени выраженности патологического процесса) призвана предотвратить развитие тяжелых форм заболеваний. Необходимо при возникновении неприятных симптомов обращаться к врачу и не заниматься самолечением.
Диагностика цистита осуществляется при помощи осмотра, пальпации мошонки и простаты. Кроме этого, необходимо сдать урогенитальный мазок, провести бакпосев и определить возбудителя цистита.
Для лечения используются противомикробные препараты, которые помогут устранить возбудителя инфекции мочевого пузыря и мочевыводящих путей. Полезным будет прием растительных препаратов, которые окажут противовоспалительный и мочегонный эффект, среди них большой популярностью пользуются фиточаи, таблетки с экстрактом клюквы и клюквенные морсы.
Для заболевания характерны резкие острые или тупые боли, которые локализуются преимущественно в поясничной области, боку и внизу живота. При схваткообразных приступах боль может распространяться на паховую область, отдавать в яичко или бедро. Также наблюдаются частые позывы к мочеиспусканию, которые являются затрудненными, в моче может появляться кровь.
Урологические заболевания, симптомы и проявления которых вызывают сильный дискомфорт, необходимо как можно быстрее диагностировать и эффективно лечить.
При отсутствии пиелонефрита (воспаления почек) достаточно скорректировать рацион питания и принимать спазмолитические препараты. Если же мочекаменная болезнь сопутствует пиелонефриту, необходимо применение антибиотиков.
Баланопостит легко определить по наличию эрозивных высыпаний на головке члена и крайней плоти. Кроме этого, заболевание сопровождается отечностью и болезненностью половых органов, наблюдаются гнойные выделения, в некоторых случаях присутствуют белые наросты.
При остром течении болезни температура тела поднимается, в теле ощущается слабость, которая может доходить до обморочных состояний. Хроническая форма баланопостита характеризуется сморщиванием кожи головки и крайней плоти.
Основными лекарственными препаратами являются антибиотики и противогрибковые средства, также необходимо использовать местные мази и иммуностимуляторы, что в комплексе позволит устранить причину заболевания и повысить защитные силы организма, ускоряя тем самым процесс выздоровления.
Наука, позволяющая быстро диагностировать и лечить мужские болезни, — урология. Симптомы заболеваний дают возможность определиться с необходимым перечнем дополнительных анализов и позволяют точнее поставить диагноз, обеспечив тем самым эффективное и быстрое лечение.
- Аденома предстательной железы
- Возникновение орхоэпидидимита
- Появление простатита
- Фимоз — детская болезнь
- Профилактика мужских болезней
Заболевания из области урологии мужской часто игнорируются представителями сильного пола, поэтому обращаются они в больницу гораздо реже, чем женщины.
Болезнь пускается на самотек, и только неприятные физические ощущения (жжение, зуд, рези, недержание) заставляют задуматься о своем здоровье, посетить врача и начать лечение.
Симптомы различных урологических патологий обычно схожи, поэтому для постановки правильного диагноза всегда требуется полноценная диагностика. В любом случае нужно обратить внимание на возникновение следующих признаков, если есть подозрение на болезнь мочеполовой системы:
- Мочеиспускание становится крайне болезненным, причиняет дискомфорт, моча меняет оттенок на более темный, нездоровый. В моче присутствует кровь или другие посторонние выделения.
- Мочеиспускание становится частым, контролировать его становится сложно. Возможно возникновение непроизвольного мочеиспускания в ночное время, возрастание частоты походов туалет до двух раз в час.
- Порой возникает обратная ситуация – мочеиспускание становится слишком редким.
- Возникновение раздражения, зуда, высыпаний на половых органах. Болевые ощущения и дискомфорт могут усиливаться во время мочеиспусканий и полового акта.
- Нарушение потенции у мужчин. Также может возникать изменение цвета или запаха у спермы.
Это основные признаки патологий мочеполовой системы у женщин и мужчин, с которыми следует обязательно обратиться к врачу.
- режущие боли и жжение при посещении туалета;
- наличие специфических выделений из полового члена;
- зуд;
- учащенные мочеиспускания;
- дискомфорт в нижней части живота;
- ощущение остаточной мочи.
Наука, позволяющая быстро диагностировать и лечить мужские болезни, – урология. Симптомы заболеваний дают возможность определиться с необходимым перечнем дополнительных анализов и позволяют точнее поставить диагноз, обеспечив тем самым эффективное и быстрое лечение.
- острый простатит;
- хронический простатит либо синдром хронической тазовой боли,
- хронический бактериальный простатит.
Симптомы простатита так же разделяют на 3 группы:
- повышенное беспокойство, нервозность мужчины, которые обусловлены фиксацией внимания больных на своем состоянии.
- расстройства половой функции организма,
- расстройства со стороны мочеполовой системы, также боль в нижней части живота.
Простатит считается хроническим, если болезнь продолжается более трех месяцев.
Только у 50% больных хроническим простатитом бывают реальные болевые ощущения. У остальных наблюдаются только ослабленные, «стертые» симптомы. Для лечения хронических и острых урологических мужских болезней обычно используется безвредные и эффективные физиопроцедуры и терапия, которая направлена на подавление инфекции, устранение воспаления. Также оказывается укрепляющее воздействие на всю иммунную систему.
Тем не менее, в запущенных случаях может потребоваться операционное лечение. Например, аденома и простатит вполне могут привести к злокачественным образованиям, если вовремя не обратиться за лечением в отделении мужской урологии.
Теперь, что касается симптомов такого заболевания:
- в уретре явственное чувство дискомфорта, зудит, болит, жжет, когда мужчина идет у туалет;
- могут иметь место слизистые выделения, причем может быть и гной, не редко с добавлением пены, все это очень плохо пахнет;
- нижняя часть живота страдает от резких и спазматических болевых ощущений;
- стоит человеку сходить в туалет, как после сразу же возникает чувство, что мочевой пузырь опорожнен не полностью. Так что мужчина ходит в уборную часто, причем это сопровождается неприятными ощущениями. Многие мужчины пытаются не ходит в туалет так часто, чтобы накопить побольше мочи, но такой подход только усугубляет положение.
Бывают такие случаи, когда начинает недержание, а не редко в урине появляются кровяные примеси, что окрашивает её в красноватый оттенок.
Такая болезнь не должна лечиться самостоятельно, будет только хуже. Если недуг проходит в легкой форме и симптоматика носит смазанный характер, надо немедленно отправляться к врачу для сдачи соответствующих анализов и прохождения обследования. Недуг может быть в хронической форме, что делает его лечение очень трудным.
Для лечения может быть использована фитотерапия, причем фитопрепараты должны использоваться уже после того, как недуг вылечен. Причем, такое лечение осуществляется в виде курсов, при этом фитосредства могут чередоваться, здесь должна учитываться индивидуальная чувствительность организма человека.
Способы диагностики
Для своевременной постановки диагноза необходимо срочно обратиться к квалифицированному специалисту (урологу или дерматовенерологу). Доктор выполнит все необходимые исследования, определится с характером заболевания, а также наметит план лечения и реабилитации.
При осмотре половых органов можно определить некоторые воспалительные и инфекционные заболевания. На этом этапе также обязательно выполняется пальцевое исследование конечного отдела прямой кишки с целью выявления новообразований предстательной железы.Для точной диагностики уролог прибегает к лабораторным и инструментальным методам обследования.
Так же больному при необходимости выполняется уретроскопия или цистоскопия. Она представляет собой осмотр стенок уретры и мочевого пузыря изнутри при помощи эндоскопического оборудования. При таком исследовании можно выявить некоторые дефекты слизистой этих органов.Очень информативным методом исследования при урологической патологии является ультразвуковое исследование почек, мочевыводящих путей и простаты.
Диагностика урологических заболеваний у мужчин включает проведение таких современных методов, как УЗИ почек и мочевыводящих путей, цистоскопия, ретроградная уретеропиелография, уретроскопия, экскреторная урография и различные лабораторные исследования мочи. Также для своевременного выявления урологических заболеваний существуют отдельные методы исследования мочеполовой системы мужчины.
Прежде всего, диагностика должна начинаться с опроса пациента, сексологического исследования и осмотра половых органов. Врач после этого проводит пальпацию. Обязательно назначаются лабораторные исследования мочи, крови и семенной жидкости. При необходимости проводится рентгеноскопия, применяются радиоизотопные и инструментальные методы исследования.
К рентгенологическим методам диагностики можно отнести: уретрографию (заполнение уретры рентгенологическим веществом, затем делается снимок, при котором выявляются патологии уретры), везикулографию (исследование семенных пузырьков), эпидидимографию (исследование придатка яичка), простатографию (рентген предстательной железы).
Лечение любой урологической болезни должно быть комплексным, но в первую очередь необходимо устранить причину ее возникновения. Лечение уретрита включает в себя прием антибактериальных препаратов, которые назначает лечащий врач после лабораторного исследования урогенитального мазка и определения вида микрофлоры, которая присутствует в уретре.
Для лечения баланопостита назначается промывание крайней плоти и головки полового члена раствором фурацилина или перекиси водорода. Места поражения обязательно нужно обрабатывать антисептическими мазями. Также показан прием антибиотиков, противовирусных или противогрибковых препаратов. В некоторых случаях даже прибегают к хирургическому вмешательству.
Если крайняя плоть слишком сужена, то тогда потребуется операция по ее рассечению. Как только симптомы воспаления уменьшатся, нужно будет провести операцию по полному обрезанию крайней плоти. В самых сложных ситуациях показана операция по подвешиванию краев уретры к краям головки пениса. Возможны еще лазерные хирургические операции.
Основным методом лечения аденомы простаты является хирургическое вмешательство. Кроме того, показан прием альфа-аденоблокаторов и антибиотиков, иммуностимулирующая терапия и физиотерапевтическое лечение.
Лечение простатита, помимо приема антибиотиков, альфа-аденоблокирующих препаратов и иммуностимуляторов обязательно должно включать массаж предстательной железы. Это нужно для улучшения кровоснабжения и питания простаты. При массаже происходит восстановление ее функции. Данная процедура должна поводиться через прямую кишку, при этом пациент лежит на боку, а мочевой пузырь наполнен.
Цистит, пиелонефрит и мочекаменная болезнь лечатся комплексно с использованием антибактериальных препаратов и симптоматической терапии. При недержании мочи рекомендовано применение специальных урологических прокладок для мужчин, которые защищают одежду от пропитывания непроизвольно выделяющейся мочой. Они разработаны специально для облегчения социализации больных, страдающих данным недугом.
Профилактика урологических заболеваний заключается в первую очередь в своевременном и регулярном обследовании у врача-уролога. В холодное время года нужно носить теплую одежду (закрывающую поясницу и половые органы), следует отказаться от холодного купания (если организм не закален). Чтобы не нарушить приток крови к урологическим органам, необходимо отказаться от узкой и стягивающей одежды.
Каким образом лечится простатит
У мужчин, находящихся в репродуктивном возрасте (примерно от 18 до 45 лет), чаще всего встречаются следующие заболевания:
- Связанные с воспалительными процессами в мочевыделительной и половой системе, а также воспалениями, локализующимися в половых органах.
- Венерические заболевания — инфекции и вирусы, передающиеся преимущественно половым путем.
- Связанные с половой сферой, в частности бесплодие или импотенция.
Для лечения перечисленных патологий необходимо пройти обследование и установить верный диагноз. После этого врач назначит подходящее лечение и будет следить за течением симптомов и размножением вредных бактерий. В норме через короткий промежуток времени все симптомы исчезают, и здоровье мужчины становится прежним.
Чтобы вылечить урологические заболевания у мужчин, симптомы которых схожи с симптомами уретрита, необходимо посетить врача и сдать урогенитальный мазок. В качестве основного лекарства используются антибактериальные препараты, вместе с ними обязательно нужно принимать иммуностимулирующие комплексы, ускоряющие процесс излечения.
Для предотвращения развития дисбактериоза нужно совмещать прием антибиотиков с подходящими пробиотиками. Дополнительно можно вводить в мочеиспускательный канал антисептические растворы.
В лечении урологических заболеваний у мужчин важно учитывать причины развивающейся патологии. Терапия должна быть направлена на устранение инфекционного процесса, а также ликвидацию симптомов.
- Рибомунил,
- Бифиформ и другие лекарства.
Введение в уретру антисептического раствора помогает избавиться от патогенных микроорганизмов, вызывающих инфекцию и воспаление.
Лечение назначает врач после выявления патогенного возбудителя. Антибактериальный препарат применяется в зависимости от присутствующей в уретре микрофлоры. Назначаются:
- Ампициллин,
- Амоксициллин,
- Цефтибутен,
- Норфлоксацин,
- Левофлоксацин,
- Фосфомицин.
Чтобы восстановить функции предстательной железы, показано комплексное применение лекарств. Терапия включает применение препаратов, которые ликвидируют инфекционно-воспалительный процесс в тканях половых органов. Используются средства, действие которых направлено на устранение болезненности, и восстановление мочеиспускания. Чтобы процесс не перешёл в хроническую стадию, в лечении требуются антибиотик и антисептики.
Из иммуномоделирующих препаратов применяются Пирогенал, Риоферон. В комплексной терапии аденомы простаты применяются альфа-адреноблокаторы и антибиотики. Хорошо помогают массажи простаты через прямую кишку и различные физиопроцедуры.
- При недержании мочи используются специальные урологические изделия, которые впитывают непроизвольно выделяющуюся жидкость. Прокладка защищает нижнее бельё пациента и облегчает социализацию больного человека.
- В особо сложных ситуациях выполняется хирургическое вмешательство или обрезание крайней плоти. Расширение наружного отверстия мочеиспускательного канала способствует устранению воспалительного процесса и его симптомов.
В качестве дополнительных методов лечения необходимо:
- наладить режим дня,
- половую активность,
- перейти на сбалансированный рацион питания.
В комплексной терапии недугов используются отвары и настои из различных лекарственных трав. Помогают избавиться от урологических болезней шиповник, зверобой, брусника, васильки, крапива, земляника. Народные рецепты эффективно устраняют воспалительный процесс в мочевыводящих путях и способствуют быстрому выздоровлению.
В зависимости от заболевания и причины его возникновения подбирается подходящее лечение. Обычно оно включает в себя различные обезболивающие противовоспалительные средства, при бактериальных поражениях требуются антибиотики местного или системного применения.
При ряде заболеваний и запущенных патологиях может потребоваться хирургическое вмешательство, однако при своевременном начале лечения его, как правило, можно избежать.
- Связанные с воспалительными процессами в мочевыделительной и половой системе, а также воспалениями, локализующимися в половых органах.
- Венерические заболевания – инфекции и вирусы, передающиеся преимущественно половым путем.
- Связанные с половой сферой, в частности бесплодие или импотенция.
Для подтверждения болезненного диагноза уролог, как правило, назначает исследование железы ультразвуковым методом. Очень важно выявить основной возбудитель болезни, для этого сдается поскреб и посев. После этого настает черед медикаментозных препаратов, которые способы эффективно подавить инфекцию. Что касается снятия болевых ощущений, то здесь на помощь приходят анальгетики.
Хорошо помогает и лечебный массаж, если его пройти, то явления застойного типа в венах простаты, ликвидируются. С помощью лечебного массажа можно бороться с отеками и болезненными ощущениями. Если посещать сеансы массажа на регулярной основе, то можно полностью излечиться от коварного недуга и восстановить все функции органа.
Терапия некоторых урологических болезней
Лечение мужских болезней обязательно должно быть всесторонним, и в первую очередь быть направленным на борьбу с этиологическими факторами.
1. При лечении уретритов применяются:- антибиотики, которые подбираются врачом после исследования мазка на наличие микроорганизмов, а иногда и после определения чувствительности микрофлоры к препаратам;- неспецифические противовоспалительные средства, для снятия болезненности и дизурии- местные антисептические растворы для санации уретры;
2. При баланопостите обязательно требуется:- антибактериальные препараты;- противогрибковые препараты;- санация данной области фурацилином, мирамистином, хлоргексидином и аналогичными антисептическими средствами;- нанесение мазей с антибиотиками или антисептиками;- так же может применяться хирургический метод лечения (рассечение или обрезание крайней плоти с целью обеспечить более широкий доступ для санации и гигиенических процедур);
3. Аденома предстательной железы лечится в основном хирургическим путем. Так же назначают антибактериальную терапию и иммуностимулирующие средства.
4. Для лечения простатита используют:- антибактериальные средства;- адреноблокаторы;- иммуномодуляторы;- физиотерапия;- массаж простаты.Массаж простаты применяют чаще при хроническом течении простатита с целью улучшить ее трофику и кровообращение в ней. Выполнять массаж железы должен только врач в поликлинических условиях.
5. Для борьбы с циститом и пиелонефритом используются в основном антибиотики, мочегонные средства и иммуностимуляторы;
6. Лечение мочекаменной болезни может быть, как консервативным (спазмолитики, литотрипсия), так и оперативным (извлечение крупных конкрементов из почек и мочеточников при полостной операции);Надо отметить, что сейчас для пациентов, страдающих недержанием мочи, выпускаются специальные мужские впитывающие прокладки, защищающие одежду. Это повышает качество жизни и социальную адаптацию мужчин, страдающих недержанием мочи.
Чтобы избежать урологической болезни у мужчины, урологи рекомендуют придерживаться здорового образа жизни. Вредные привычки крайне негативно влияют на функции мочеполовой системы.
Заболевания провоцируют:
- переохлаждения,
- несоблюдение необходимых гигиенических правил,
- попадание внутрь уретры инфекции.
Незащищённый половой акт часто становиться причиной инфицирования и развития уреаплазмоза. Организму может угрожать развитие урологического недуга при сниженном иммунитете. Необходимо регулярно поддерживать функции иммунной системы в норме – побольше гулять на свежем воздухе, правильно питаться и выполнять умеренные спортивные нагрузки. Занятия спортом способствуют избавлению от застойного процесса в мужских мочеполовых органах.
Заболевание может быть вызвано употреблением некоторых лекарств. Не следует принимать препараты, провоцирующие проблемы с уретрой. Каждому мужчине следует знать, что игнорирование урологической болезни приводит к тяжёлому осложнению.
Вам все еще кажется, что улучшить потенцию невозможно?
Судя по тому, что вы сейчас читаете эти строки — победа в борьбе с эректильной дисфункцией пока не на вашей стороне…
И вам не дает покоя эта проблема? Оно и понятно, ведь плохая потенция не дает уверенно чувствовать себя в постели и жить полноценной половой жизнью. Разочарование девушек, снижение либидо и потеря уверенности в себе… Все это знакомо вам не понаслышке.
Основная профилактика любых заболеваний такого рода – поддержание личной гигиены, особенно это касается маленьких детей. Следует регулярно подмываться и менять нижнее белье. Также важно поддерживать иммунитет, вероятность развития инфекционных патологий заметно снижается, если защитные силы организма активны.
Также всегда следует использовать средства предохранения при половых контактах. Множество различных бактериологических и иных инфекций, способных провоцировать разные заболевания, передается половым путем.
Для мужчин, особенно в старшем возрасте, особенно важно поддерживать нормальный уровень физической активности. Сидячий образ жизни способен привести ко многим патологиям в области таза.
Урологические болезни у мужчин удачно излечиваются, если процессы не приобрели хронический характер. Способ терапии выбирается на основе изучения всех данных анамнеза, осмотра и показателей анализов. Лечение уретритов предполагает употребление антибактериальных медикаментов, иммуномодуляторов и микронутриентов.
Лечение простатита и гиперплазии предстательной железы включает прием антибактериальных средств, альфа-адреноблокаторов, иммуностимуляторов. Для снятия симптомов простатита важно проведение массажа. Таким образом усиливается функциональность предстательной железы, поступление питательных веществ и кровоснабжение.
Массирование также необходимо для взятия секреторной жидкости. При подозрении на злокачественную опухоль массаж железы противопоказан. Урологические заболевания в форме цистита, мочекаменной патологии лечатся с помощью антибиотиков. В случае недержания урины применяются специальные урологические салфетки для мужчин.
Лечение урологических недугов хирургическим методом показано в случае серьезных нарушений функционала почек, мочевого органа. При мочекаменной болезни проводится дистанционная литотрипсия. При гипертрофии простаты врач может назначить трансуретральную резекцию органа. Чтобы не доводить дело до применения кардинальных мер, необходимо соблюдать гигиену половой жизни, не переохлаждаться, правильно питаться и не злоупотреблять алкоголем.